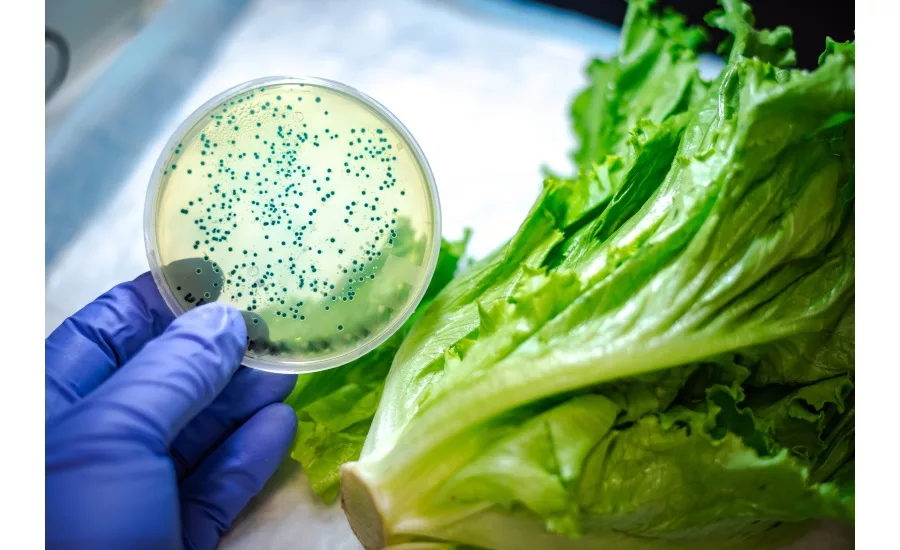
Innovative treatment prevents spread of bacteria across metal surfaces

Innovative treatment prevents spread of bacteria across metal surfaces
Researchers at Purdue University have developed a treatment to infuse a hardened metal surface with naturally occurring antimicrobial peptides.
The Purdue team’s technology creates a hard metal surface that kills bacteria that try to attach to the surface.
“When we create an oxidized metal surface with nanometer-wide and micrometer-deep cracks, peptides can be infused in these microscopic cracks with a simple wet process,” said David Bahr, head and professor of materials engineering at Purdue, who leads the team. “As an additional benefit, the process can color several metals, providing a visual indication of when the surface is no longer antimicrobial.”
Bahr said this technology applies primarily to food processing and cutting surfaces, which can be especially vulnerable to bacteria growth and attachment given the materials and surface designs.
“Our technology can help ensure that if a food processing facility was chopping salad greens, bacteria would not transfer from a contaminated surface to a cutting tool, thereby contaminating many more parts,” Bahr said. “When used in conjunction with food washing and other safe handling, this should allow fewer outbreaks of foodborne illness.”
Preliminary testing verified that the treated surfaces provide antibacterial properties in excess of the untreated surfaces. The material stored in the cracks releases over time, leading to extended times of antimicrobial resistance.
The oxidation process creates an optically colored material, which provides a simple visual indicator of wear or degradation in antimicrobial performance.
Looking for quick answers on food safety topics?
Try Ask FSM, our new smart AI search tool.
Ask FSM →
The process has been demonstrated on stainless steel and titanium and is applicable to a wide range of commercial metal alloys.
The team worked with the Purdue Research Foundation Office of Technology Commercialization to patent the technology.
The creators are looking for partners to commercialize their technology. For more information on licensing this innovation, contact Dipak Narula of OTC at dnarula@prf.org and reference track code 2017-BAHR-67842.








